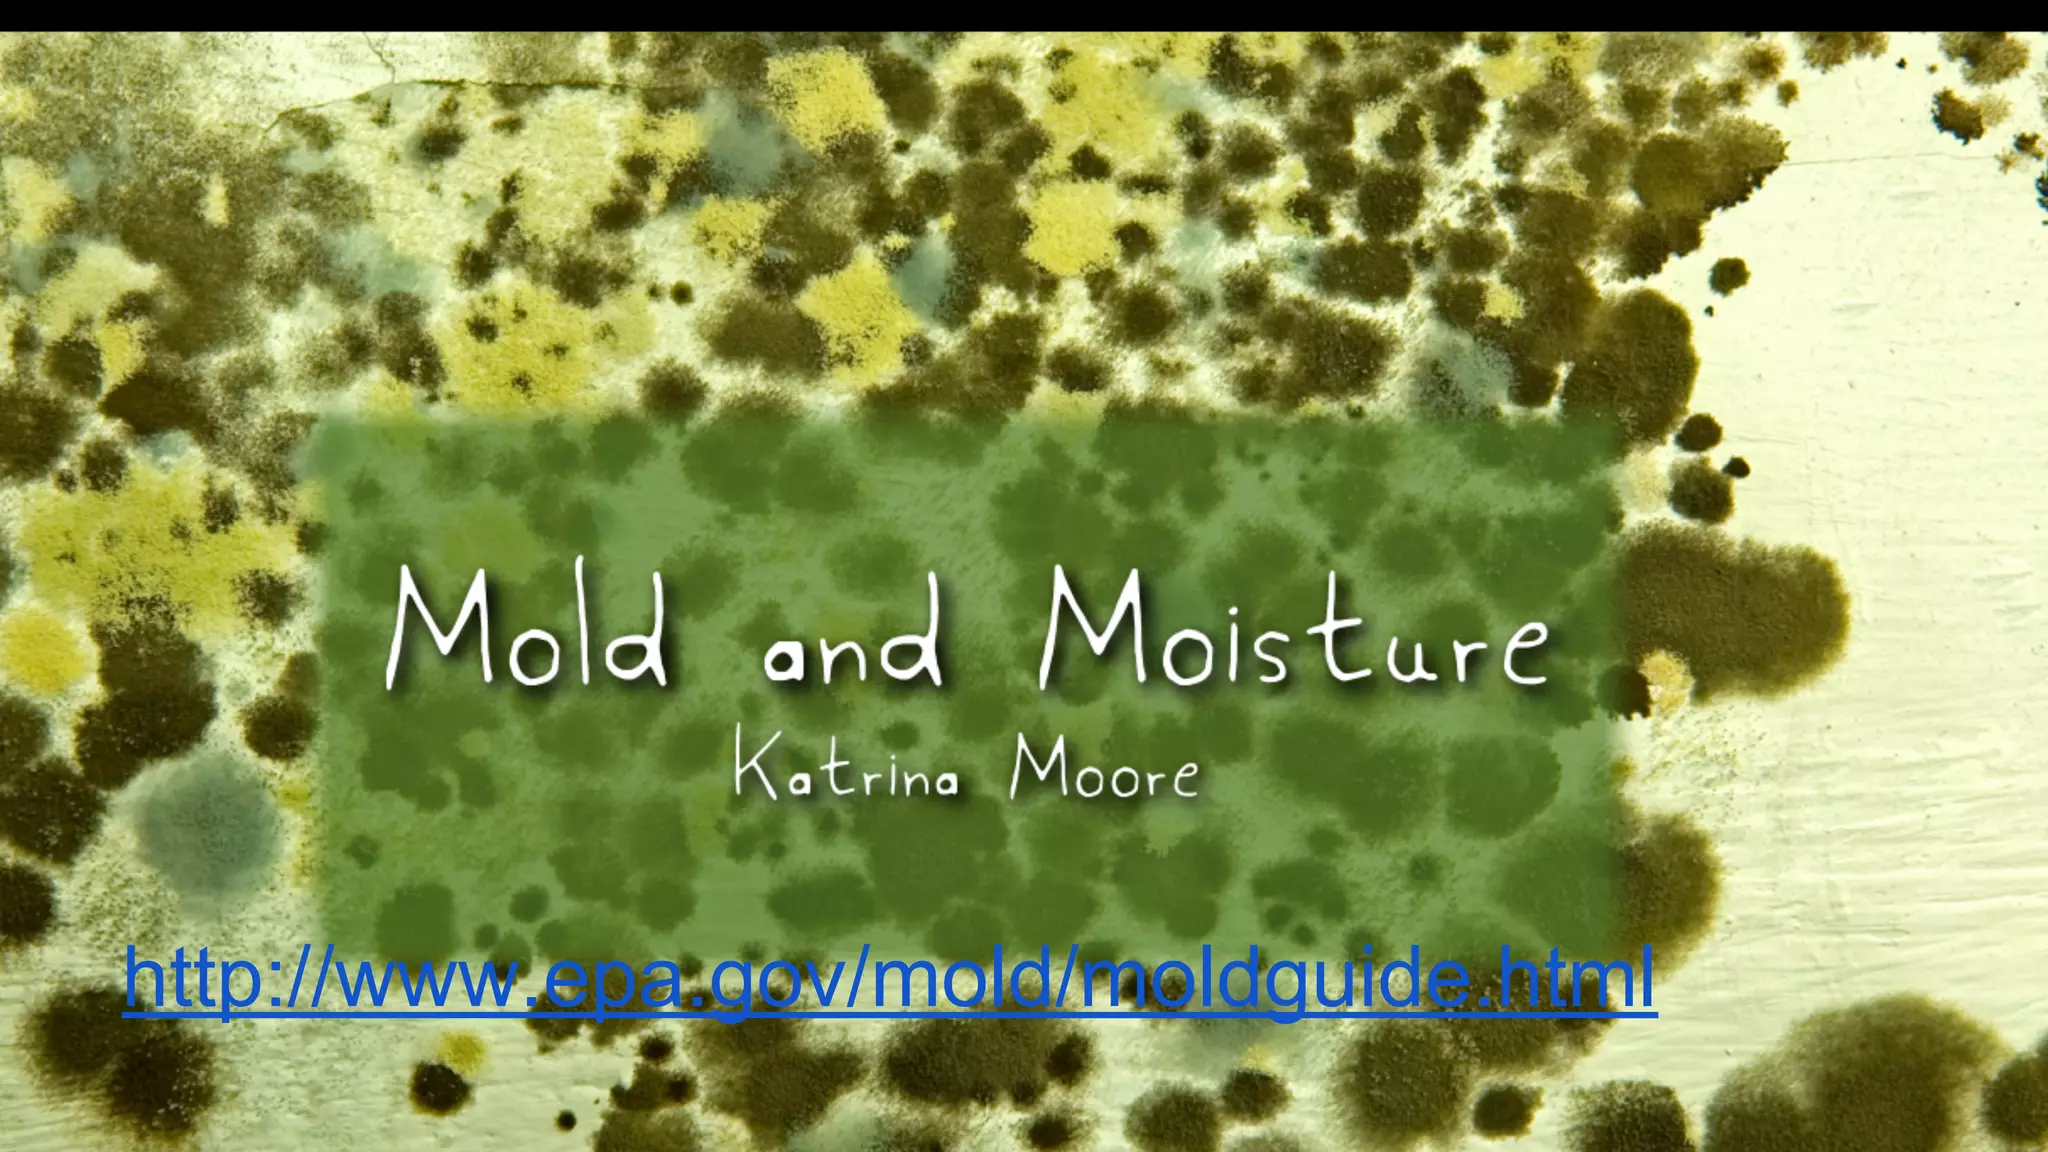
http://www.epa.gov/mold/moldguide.html
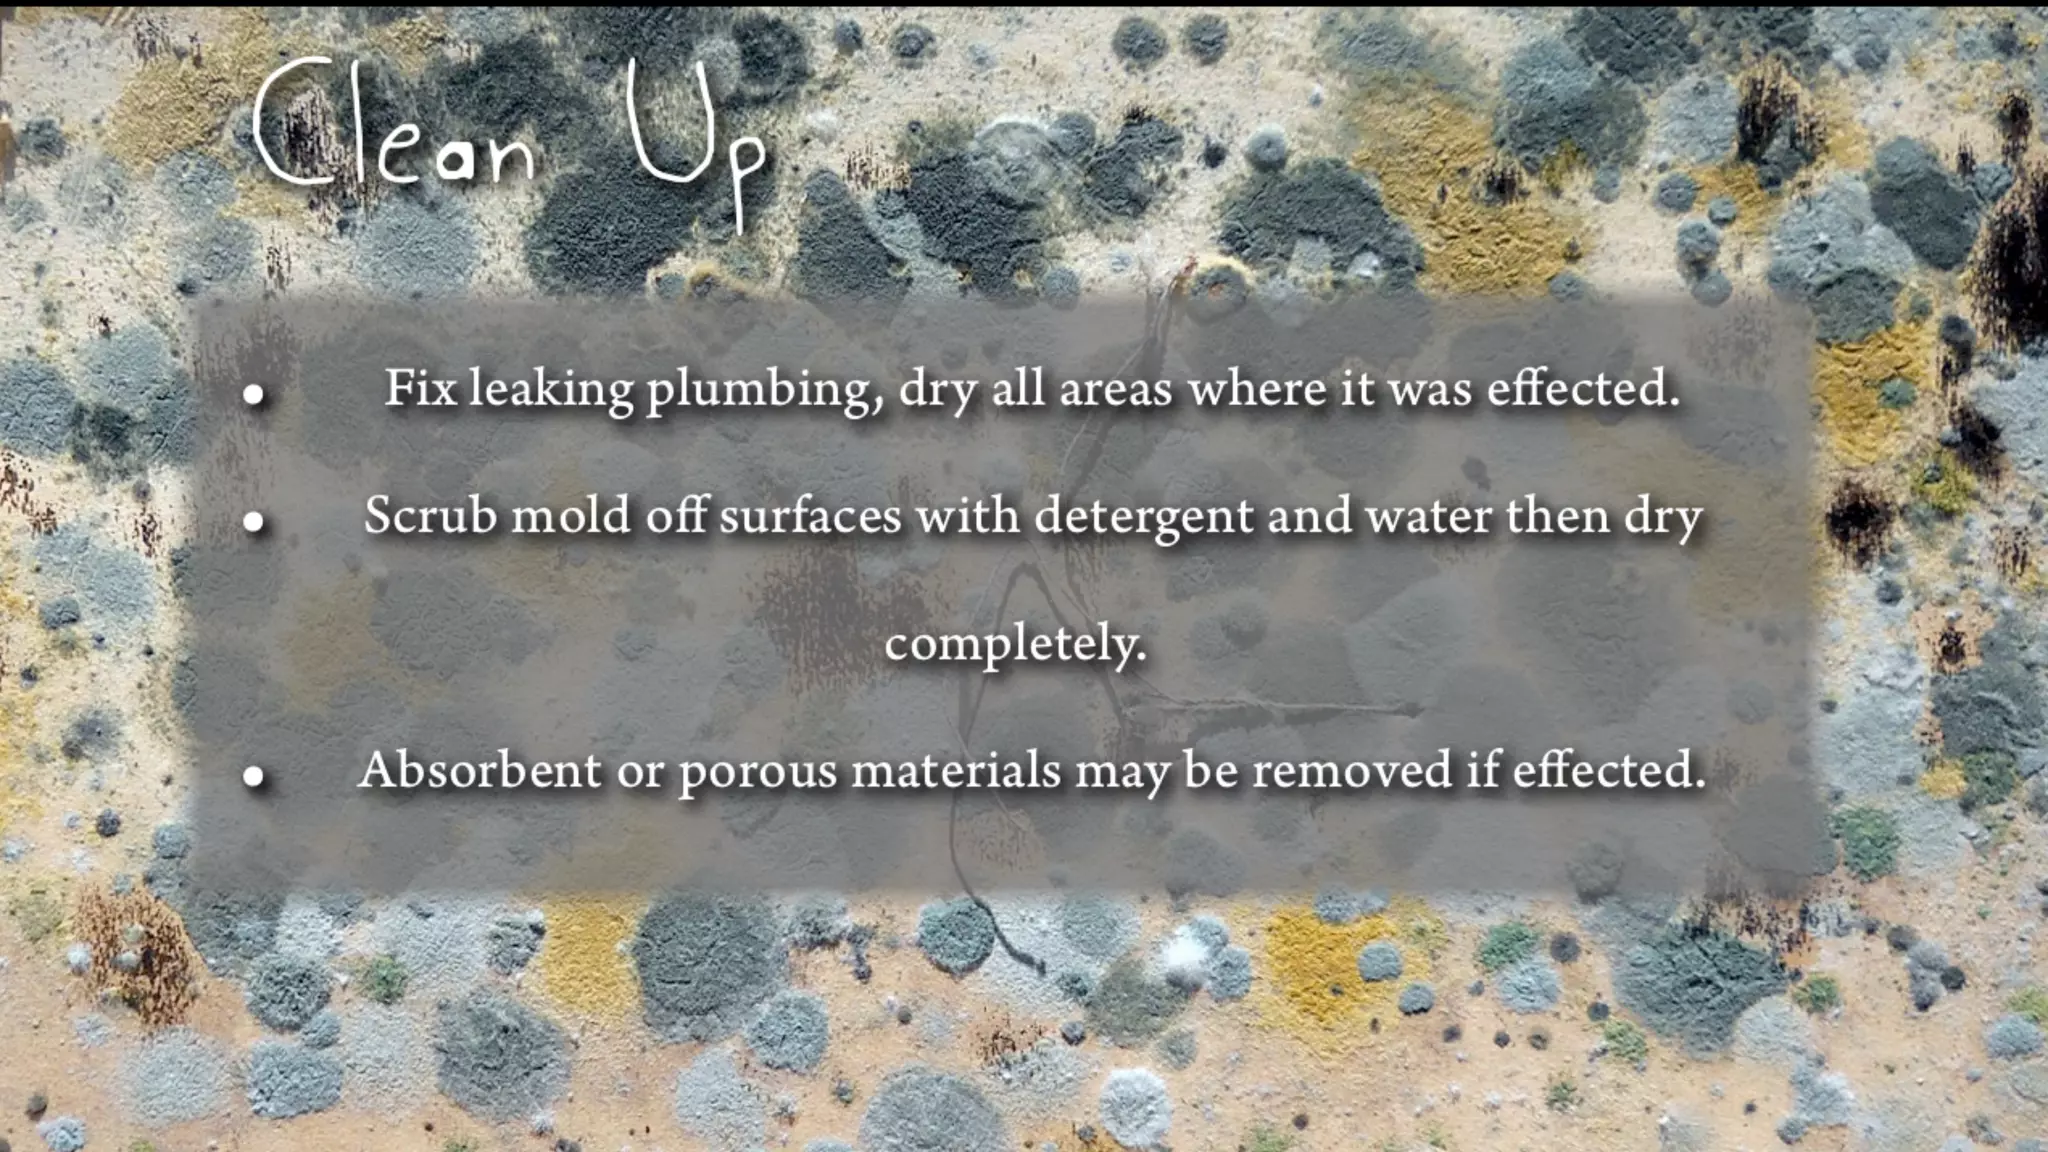
Unit 11  Pollution

This document discusses primary and secondary air pollutants. It defines primary pollutants as those emitted directly from sources, while secondary pollutants form when primary pollutants react in the atmosphere. Examples of primary pollutants include carbon monoxide, sulfur dioxide, nitrogen oxides, hydrocarbons, and particulate matter. Secondary pollutants include ozone, nitrogen dioxide, and acid rain. The document also discusses specific primary pollutants like carbon monoxide and secondary pollutants like ground-level ozone, their sources and health effects. It addresses aerosols, smog, and laws enacted to control air pollution.